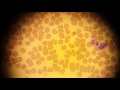

ЧТО ТАКОЕ ПЕРСТНЕВИДНОКЛЕТОЧНЫЙ РАК ЖЕЛУДКА
Перстневидноклеточный рак желудка (часто также называемый аденокарциномой) - это злокачественная опухоль, которая развивается из железистых клеток слизистой оболочки желудка.
Этот вид рака является одной из наиболее распространенных форм рака желудка. Он характеризуется формированием гистологических структур, напоминающих колечко или перстень, что и привело к его названию.
Перстневидноклеточный рак желудка обычно не вызывает ранних симптомов, что может затруднить его диагностику. Как правило, симптомы возникают уже на поздних стадиях заболевания, когда опухоль становится большой или начинает распространяться на окружающую ткань.
Ранние признаки перстневидноклеточного рака желудка могут включать неспецифические симптомы, такие как дискомфорт в желудке, дополнительные ощущения при приеме пищи, увеличение чувства насыщения или потеря аппетита.
При наличии подозрения на перстневидноклеточный рак желудка необходимо провести диагностические исследования, которые могут включать гастроскопию с биопсией опухоли для получения тканей для дальнейшего анализа.
Лечение перстневидноклеточного рака желудка зависит от стадии распространения опухоли. Обычно используются комбинированные методы, такие как хирургическое удаление опухоли, химиотерапия, лучевая терапия или их комбинация.
Важно отметить, что каждый пациент индивидуален, и план лечения определяется врачом в соответствии с конкретной клинической ситуацией.
Для предотвращения перстневидноклеточного рака желудка рекомендуется соблюдать здоровый образ жизни, включающий балансированное питание, регулярную физическую активность и отказ от курения.
Перстневидноклеточный рак желудка
Перстневидноклеточный рак желудка. Изменит ли это тактику лечения? ДА
Перстневидноклеточный рак желудка - Патанатомия
История пациента МКНЦ: рак желудка и пищевода
Рак Желудка - Перстневидноклеточный тип опухоли желудка. Прогноз на ранних стадиях заболевания.
Лечится ли рак желудка?
08Live Ткаченко ОБ Перстневидноклеточный рак двенадцатиперстной кишки cEMR PENTAX 7010